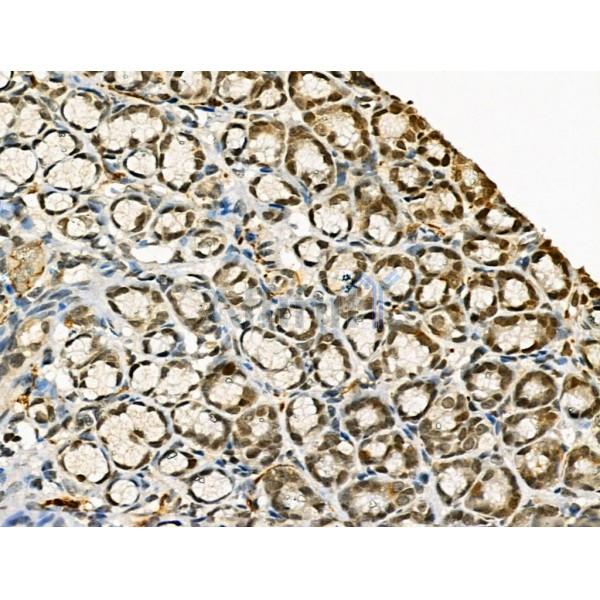
Phospho-RAD18 (Ser471) Antibody - AF3530 at 1/100 staining Rat stomach tissue by IHC-P.

Phospho-RAD18 (Ser471) Antibody - #AF3530
| Product: | Phospho-RAD18 (Ser471) Antibody |
| Catalog: | AF3530 |
| Description: | Rabbit polyclonal antibody to Phospho-RAD18 (Ser471) |
| Application: | IHC |
| Reactivity: | Human, Mouse, Rat |
| Mol.Wt.: | 80,90kD; 56kD(Calculated). |
| Uniprot: | Q9NS91 |
| RRID: | AB_2846844 |
Product Info
*The optimal dilutions should be determined by the end user. For optimal experimental results, antibody reuse is not recommended.
*Tips:
WB: For western blot detection of denatured protein samples. IHC: For immunohistochemical detection of paraffin sections (IHC-p) or frozen sections (IHC-f) of tissue samples. IF/ICC: For immunofluorescence detection of cell samples. ELISA(peptide): For ELISA detection of antigenic peptide.
Cite Format: Affinity Biosciences Cat# AF3530, RRID:AB_2846844.
Fold/Unfold
2810024C04Rik; DNA repair protein rad18; E3 ubiquitin-protein ligase RAD18; EC 6.3.2.-; hHR 18; hHR18; hRAD 18; hRAD18; MGC156682; Postreplication repair E3 ubiquitin-protein ligase RAD18; Postreplication repair protein hRAD18p; Postreplication repair protein RAD18; RAD 18; RAD18; RAD18 homolog (S. cerevisiae); RAD18 homolog; RAD18 S. cerevisiae homolog; RAD18 S. cerevisiae homolog of; RAD18 transcript variant; RAD18_HUMAN; Rad18sc; Radiation sensitivity protein 18; RING finger protein 73; RNF 73; RNF73; Structural maintenance of chromosomes protein 6; YCR066W; YCR66W;
Immunogens
A synthesized peptide derived from human RAD18 around the phosphorylation site of Ser471.
- Q9NS91 RAD18_HUMAN:
- Protein BLAST With
- NCBI/
- ExPASy/
- Uniprot
MDSLAESRWPPGLAVMKTIDDLLRCGICFEYFNIAMIIPQCSHNYCSLCIRKFLSYKTQCPTCCVTVTEPDLKNNRILDELVKSLNFARNHLLQFALESPAKSPASSSSKNLAVKVYTPVASRQSLKQGSRLMDNFLIREMSGSTSELLIKENKSKFSPQKEASPAAKTKETRSVEEIAPDPSEAKRPEPPSTSTLKQVTKVDCPVCGVNIPESHINKHLDSCLSREEKKESLRSSVHKRKPLPKTVYNLLSDRDLKKKLKEHGLSIQGNKQQLIKRHQEFVHMYNAQCDALHPKSAAEIVREIENIEKTRMRLEASKLNESVMVFTKDQTEKEIDEIHSKYRKKHKSEFQLLVDQARKGYKKIAGMSQKTVTITKEDESTEKLSSVCMGQEDNMTSVTNHFSQSKLDSPEELEPDREEDSSSCIDIQEVLSSSESDSCNSSSSDIIRDLLEEEEAWEASHKNDLQDTEISPRQNRRTRAAESAEIEPRNKRNRN
Research Backgrounds
E3 ubiquitin-protein ligase involved in postreplication repair of UV-damaged DNA. Postreplication repair functions in gap-filling of a daughter strand on replication of damaged DNA. Associates to the E2 ubiquitin conjugating enzyme UBE2B to form the UBE2B-RAD18 ubiquitin ligase complex involved in mono-ubiquitination of DNA-associated PCNA on 'Lys-164'. Has ssDNA binding activity.
Nucleus. Cytoplasm>Cytoskeleton>Microtubule organizing center>Centrosome.
Note: Associates with chromatin (PubMed:25931565). Colocalizes with SLF1 in the nucleus and to centrosomes (PubMed:15632077). Relocalizes with SLF1 to nuclear foci in response to DNA damage (PubMed:22036607). Accumulates with the SLF1-SLF2 and SMC5-SMC6 complexes at replication-coupled DNA interstrand repair and DNA double-strand breaks (DSBs) sites on chromatin in a ubiquitin-dependent manner (PubMed:25931565).
Belongs to the RAD18 family.
Restrictive clause
Affinity Biosciences tests all products strictly. Citations are provided as a resource for additional applications that have not been validated by Affinity Biosciences. Please choose the appropriate format for each application and consult Materials and Methods sections for additional details about the use of any product in these publications.
For Research Use Only.
Not for use in diagnostic or therapeutic procedures. Not for resale. Not for distribution without written consent. Affinity Biosciences will not be held responsible for patent infringement or other violations that may occur with the use of our products. Affinity Biosciences, Affinity Biosciences Logo and all other trademarks are the property of Affinity Biosciences LTD.